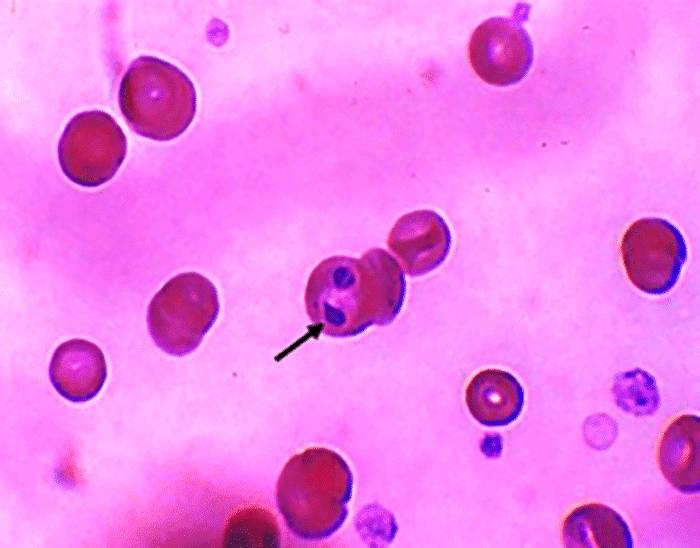
Чем вызывается бабезиоз у человека?

Возбудитель
Бабезиоз у человека возникает из-за попадания в организм паразитов, относящихся к группе споровиков. Заболевание вызывается тремя видами возбудителей, два из которых встречаются в Европе, а один – в Северной и Южной Америке. Развитие болезни происходит при значительном увеличении численности колонии паразитов и, как правило, протекает в острой форме. Основные симптомы включают лихорадку, интоксикацию и тяжелую анемию.
Эта болезнь считается относительно новой, так как впервые диагноз был установлен лишь в середине 20 века. Тем не менее, современные методы лечения показывают высокую эффективность. Поэтому прогноз для большинства пациентов обычно благоприятный. Полное выздоровление возможно после одного курса медикаментозной терапии.
Некоторые виды возбудителей могут вызывать заболевание у животных, в основном у сельскохозяйственных животных и собак. Инфекция может передаваться от животных к человеку. Паразиты данной группы распространены на всех континентах, кроме Антарктиды, и переносятся насекомыми, преимущественно пастбищными клещами.
Паразит является внутриклеточным и обитает в эритроцитах. В научной литературе зарегистрировано всего около 100 случаев заболевания у людей. Однако существует мнение, что реальное количество зараженных значительно выше, так как часто ставится неверный диагноз. В некоторых случаях заболевание может приводить к летальному исходу.
Бабезиоз у человека вызывается паразитами рода Babesia, которые передаются через укусы инфицированных клещей. Врачи отмечают, что наиболее распространенными переносчиками являются клещи семейства Ixodidae. При укусе клеща паразиты попадают в кровь, где начинают размножаться, поражая эритроциты. Это может привести к различным симптомам, включая лихорадку, озноб, головную боль и мышечные боли. Врачи подчеркивают, что риск заражения особенно высок в летний период, когда активность клещей возрастает. Профилактика включает использование репеллентов и защитной одежды, а также регулярные осмотры после пребывания на природе. Раннее обращение к врачу при появлении симптомов может значительно улучшить прогноз и снизить риск осложнений.

Пути заражения
Пути заражения пока недостаточно исследованы. Известно, что основными переносчиками болезни являются клещи. Инфекция передается через их укусы. Наиболее опасными считаются иксодовые клещи, но только некоторые из них, относящиеся к родам Дермацентор и Рипицефалус. Передача инфекции происходит, когда слюна клеща попадает в кровь человека во время укуса.
Споровики требуют двух хозяев для своего жизненного цикла. Окончательными хозяевами являются крупные теплокровные млекопитающие, такие как человек или животные. В качестве промежуточного резервуара выступают мелкие грызуны.
Существует мнение, что после перенесенного заболевания у людей и животных формируется специфический иммунитет, так как замечено, что они становятся невосприимчивыми к болезни на срок от 2 до 3 лет.
Для профилактики заболевания у человека важно избегать укусов клещей и использовать специальные противоклещевые средства. Также рекомендуется минимизировать контакт с потенциально зараженными животными.
| Фактор | Описание | Влияние на бабезиоз |
|---|---|---|
| Возбудитель | Простейшие рода Babesia (например, Babesia microti, Babesia divergens, Babesia duncani) | Непосредственно вызывают заболевание, паразитируя в эритроцитах человека. |
| Переносчик | Иксодовые клещи (например, Ixodes scapularis в Северной Америке, Ixodes ricinus в Европе) | Передают возбудителя от инфицированных животных (грызунов, оленей) человеку при укусе. |
| Резервуарные хозяева | Мелкие млекопитающие (грызуны, такие как белоногие мыши), олени | Являются естественными носителями паразита, поддерживая его циркуляцию в природе и обеспечивая заражение клещей. |
| Географическое распространение | Регионы с высокой численностью инфицированных клещей и резервуарных хозяев (например, северо-восток США, некоторые районы Европы) | Определяет вероятность контакта человека с зараженными клещами и, соответственно, риск заражения. |
| Иммуносупрессия | Состояния, ослабляющие иммунную систему (например, ВИЧ/СПИД, химиотерапия, спленэктомия) | Увеличивают риск развития тяжелой формы бабезиоза и осложнений, так как организм хуже справляется с инфекцией. |
| Переливание крови | Переливание крови от инфицированного, но бессимптомного донора | Редкий, но возможный путь передачи бабезиоза, особенно в эндемичных районах. |
| Возраст | Пожилой возраст, младенческий возраст | Могут быть факторами риска для более тяжелого течения заболевания из-за особенностей иммунной системы. |
Симптомы
Первые признаки заболевания начинают проявляться у человека через 6-15 дней после заражения, что зависит от типа паразита, который стал переносчиком споровика, а также от общего состояния здоровья пациента. Эти аспекты оказывают влияние на продолжительность инкубационного периода. Первым тревожным сигналом может стать резкое повышение температуры тела до 39-40 градусов. Спустя два-три дня появляются и другие симптомы:
- Учащенное дыхание;
- Нарушения сердечного ритма;
- Общее угнетенное состояние;
- Чередование запоров и диареи;
- Наличие крови в моче.
Острая фаза заболевания может продолжаться до 8 дней, после чего она переходит в хроническую стадию. Возможными осложнениями являются почечная и печеночная недостаточность, а также выраженная интоксикация и аллергические реакции.
Бабезиоз — это инфекционное заболевание, вызываемое простейшими паразитами рода Babesia, которые передаются человеку через укусы зараженных клещей. Люди часто обсуждают, как важно быть внимательными к своему здоровью, особенно в летний период, когда активность клещей возрастает. Симптомы бабезиоза могут варьироваться от легкой лихорадки и озноба до более серьезных состояний, таких как анемия и проблемы с печенью. Многие отмечают, что профилактика, включая использование репеллентов и проверку на наличие клещей после прогулок на природе, играет ключевую роль в предотвращении заболевания. Кроме того, обсуждаются случаи, когда бабезиоз может протекать бессимптомно, что делает его особенно опасным. Важно помнить, что ранняя диагностика и лечение могут значительно снизить риск осложнений.

Диагностика
Диагностика данного состояния представляет собой сложную задачу, поскольку наличие крови в моче в сочетании с повышенной температурой обычно указывает на возможное воспаление почек. Врачи часто начинают лечение антибиотиками, однако если оно не приносит результатов, это может вызвать подозрения на бабезиоз.
Существует два основных метода диагностики:
- Микроскопия мазка толстой капли крови для выявления паразитов;
- Иммуноферментный анализ.
В случаях, когда количество паразитов невелико, используется биологический метод: кровь вводят лабораторным животным и наблюдают за развитием инфекции у них.
Лечение
Бабезиоз у человека можно эффективно лечить с использованием таких медикаментов, как Клиндамицин и Хинин. В случаях тяжелого течения болезни эти препараты применяются в сочетании, назначаемом врачом. Кроме того, терапия может быть дополнена Азитромицином и Атоваквоном. В некоторых ситуациях может потребоваться переливание больших объемов крови, что также приносит положительный терапевтический результат.
Это заболевание является серьезным. Без адекватного и своевременного лечения уровень смертности может достигать 50-80%. Однако при условии, что лечение начато вовремя, прогноз становится благоприятным. Полное выздоровление может наступить в период от одной недели до одного месяца. Обычно лечение осуществляется на амбулаторной основе, но в случае осложнений может потребоваться госпитализация.

Вопрос-ответ
Что вызывает бабезиоз?
Бабезиоз, вызванный Babesia gibsoni, Babesia canis и Babesia felis, переносится клещами рода Dermacentor и Riphicephalus и является протозойным заболеванием. Собаки могут заболеть после укуса заражённым клещом, так же возможна передача от суки щенкам и при переливании заражённой крови.
Что вызывает бабеиоз?
Бабезиоз — инфекция, вызываемая паразитами рода Babesia. Это зооноз, передающийся от позвоночных к человеку через укус клеща семейства иксодовых (чаще всего Ixodidae).
Какие симптомы бабезиоза у человека?
Бабезиоз — это природно-очаговое инфекционное заболевание, вызываемое простейшими рода Babesia. Заболевание вызывает подъем температуры, интоксикацию, прогрессирующую анемию. Особенно тяжело оно протекает у людей с ослабленным иммунитетом, и тем более с иммунодефицитом, а также у лиц с удаленной селезенкой.
Кто является основными переносчиками бабезий?
Переносчиками бабезий служат клещи семейства Ixodidae.
Советы
СОВЕТ №1
Изучите информацию о бабезиозе и его переносчиках. Понимание того, как происходит заражение, поможет вам избежать контакта с клещами, которые являются основными переносчиками этого заболевания.
СОВЕТ №2
При планировании походов или прогулок на природе используйте защитную одежду и репелленты. Закрытые обувь и длинные рукава могут значительно снизить риск укусов клещей.
СОВЕТ №3
Регулярно проверяйте себя и своих домашних животных на наличие клещей после прогулок на природе. Чем быстрее вы обнаружите клеща, тем меньше вероятность заражения бабезиозом.
СОВЕТ №4
Если вы заметили симптомы, такие как высокая температура, головная боль или мышечные боли после укуса клеща, немедленно обратитесь к врачу. Раннее обращение за медицинской помощью может предотвратить серьезные осложнения.